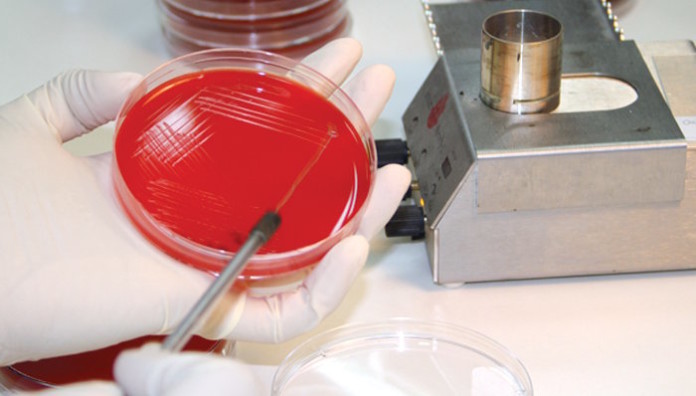

PLASMA RICO EN PLAQUETAS
Curso intensivo, presencial y en línea. Asesores especializados. Laboratorio clínico y Banco de Sangre. 6, 13 y 30 de junio 2026 de 8 a 13hs. Universidad
Juarez del Estado de Durango.
josedejesus.alba@ujed.mx
LabMedUK26 8–10 junio 2026 British Association for Chemical Pathology Eastside Rooms, Birmingham, Reino Unido https://labmed.org.uk/events-and-awards/national-meetings.html
PROBIOTA AMERICAS 2026 8 al 10 de junio 2026 –NutraIngredients / William Reed ProbiotaEvent@wrbm.comhttps://probiotaamericas.com/
PLASMA RICO en PLAQUETAS y TERAPIAS BIOLOGICASSegundo curso integral, fundamentos, aplicaciones clínicas y abordaje interdisciplinario. Asociación de Medicina Transfusional de Córdoba. En vivo por Internet sincrónico, 14, 21, 27 de junio y 4 de mayo 20256. aulademedicina@gmail.com info@aulademedicina.com.ar https://aulademedicina.com.ar/producto/curso-de-plasma-rico-en-plaquetas-y-terapia-celular-innovacion-regenerativa-y-revolucion-en-su-utilizacion-en-tratamientos-medicos-avanzados-en-vivo-por-internet /
ENDO 2026 13–16 junio 2026 Endocrine Society Annual Meeting McCormick Place West, Chicago, Illinois, USA meetings@endocrine.orgwww.endocrine.org/meetings-and-events/endo-2026-save-the-date/dates-and-info
GLOBAL MICROBIOME CONGRESS 15 y16 de junio 2026 – SciInov https://microbiomecongress.org/
CHEMISTRY WORLD CONFERENCE 18–20 junio 2026 Clinical Chemistry stream - Chemistry World Conference
Barcelona, España https://chemistryworldconference.com/program/scientific-sessions/clinical-chemistry
ICAP 2026 21–25 junio 2026 - 10th International Caparica Conference on Analytical Proteomics Costa de Caparica, Lisboa, Portugal https://icap2026.com/icap2026.com
METABOLOMICS 2026 21–24 junio 2026 Metabolomics Society congreso anual info@metabolomicssociety.orgwww.metabolomicssociety.org
IPC 2026 22 al 24 de junio 2026 International Scientific Conference on Probiotics, Gut Microbiota and Health IPC 2026 https://probiotic-conference.net/
EDM-2026 22 al 24 de junio 2026 - 7th World Congress on Endocrinology, Diabetes and Metabolism https://endocrine-diabetes.org/
VAC-LatAm26
Congreso Latinoamericano de Vacunología. 24 y 25 de junio 2026 en el Hotel Hilton de Buenos Aires. https://vacunologialatam.org/conferencia/2026/programa.html
MICROBIOTA & PROBIOTA 26–27 de junio 2026 - 4to. Summit Microbiota México –– Colegio Mexicano de Obesidad y Nutrición hola@cmon.mxwww.microbiotasummit.com/4tosummitmicrobiotamexico
SIMPOSIO SOBRE GENÓMICA Y MEDICINA PERSONALIZADA
22-24 de julio de 2026 Ciudad de México, México info@slogenomic2026.orgwww.slogenomic2026.org/simposio
ADLM 2026 26–30 julio 2026 Annual Scientific Meeting & Clinical Lab Expo Association for Diagnostics & Laboratory Medicine. Anaheim Convention Center, Anaheim, California, USA annualmeeting@myadlm.orghttp://meeting.myadlm.org/meetings-and-events/annual-meeting
TECNOLOGÍAS AVANZADAS CON APLICACIÓN EN BIOQUÍMICA CLÍNICA 6 de agosto 2026 Diplomatura Instituto Universitario de Ciencias Biomédicas de Córdoba IUCBC www.iucbc.edu.ar/cursos/diplomaturas/diplomatura-en-tecnologias-avanzadas-con-aplicacion-en-bioquimica-clinica.html
IDF-WPR & AUSTRALASIAN DIABETES CONGRESS 18–21 August 2026 Melbourne Australian Diabetes Society / Australian Diabetes Educators Association adc@theconferencecompany.comhttps://diabetescongress2026.com
ISME20 16–21 de agosto 2026 - 20th International Symposium on Microbial Ecology –– International Society for Microbial Ecology office@isme-microbes.orghttps://isme-microbes.org/events/isme20-in-auckland/
IMSC 2026 22–28 agosto 2026 - 26th International Mass Spectrometry Conference Lyon, Francia https://imsc26.com/imsc26.com
XII JORNADAS NACIONALES DE DIABETES 20–22 August 2026 Sociedad Argentina de Diabetes – SAD eventos@diabetes.org.arhttps://diabetes.org.ar/jornadas/
XXIV Congreso Peruano de Endocrinología - Endoperú 2024
22 al 24 de agosto 2026
www.endocrinoperu.org/sites/default/files/PROGRAMA%2009.08.pdf
37º CONGRESSO BRASILEIRO DE ENDOCRINOLOGIA E METABOLOGIA 26 al 29 de agosto CBEM 2026– Sociedade Brasileira de Endocrinologia e Metabologia secretaria@endocrino.org.brwww.cbem2026.com.brwww.endocrino.org.br
FASEN 2026 27 al 29 de agosto XVI Congreso de la Federación Argentina de Sociedades de Endocrinología https://fasen.org.ar/xvi-congreso-de-la-federacion-argentina-de-sociedades-de-endocrinologia
BIOMARKERS GLOBAL SUMMIT 27–28 agosto 2026 - 22nd Global Biomarkers & Clinical Research Summit
París, Francia https://biomarkers.global-summit.com
CONGRESO INTERNACIONAL DE MICROBIOLOGÍA Y NUEVAS TECNOLOGÍAS
8-10 de septiembre de 2026 São Paulo, www.microbiologia2026.com
METABOLOMICS ASSOCIATION OF NORTH AMERICA (MANA) 8–11 septiembre 2026 — 8th Annual MANA Conference www.metabolomicsna.org
64TH ANNUAL ESPE MEETING 8 al 10 de septiembre 2026 European Society for Paediatric Endocrinology www.eurospe.org/event/64th-espe-meeting
ISS MS DATA METABOLOMICS 2026 14–18 septiembre 2026 Congreso / escuela de espectrometría de masas aplicada a metabolómica. Universidad de Granada iss.metms26@ugr.eshttps://eventos.ugr.es/iss-ms-data-metabolomics-2026
NORDIC CONGRESS IN CLINICAL BIOCHEMISTRY 15–18 septiembre 2026 40th Nordic Congress, Aarhus, Dinamarca. Nordic Federation of Clinical Chemistry y Danish Society for Clinical Biochemistry–nccb2026@kongreskompagniet.dkanwlar@rm.dkhttps://conferences.au.dk/nordic-congress-in-clinical-biochemistry/
IOCDi 2026 — MDPI 23–24 septiembre 2026 1st International Online Conference on Diagnostics iocdi2026@mdpi.comhttps://sciforum.net/event/IOCDi2026SciForum
62ND EASD ANNUAL MEETING 28 September–2 October 2026 – European Association for the Study of Diabetes (EASD) – info@easd.orgwww.easd.org/annual-meeting/easd-2026/
MSACL 2026 Mass Spectrometry: Advances in the Clinical Lab MSACL Annual Conference
4–9 octubre 2026 Montréal, Canadá www.msacl.org/index.php?header=MSACL_2026MSACL
WORKSHOP INTERNACIONAL DE GENÓMICA Y BIG DATA
5-7 de octubre de 2026 Montevideo, Uruguay info@genomica2026.orgwww.genomica2026.org/workshop
XXVII COLABIOCLI 2026 7–11 octubre 2026 Congreso Latinoamericano de Bioquímica Clínica Santa Cruz de la Sierra, Bolivia www.colabiocli.com
SEMINARIO SOBRE METABOLÓMICA Y MICROBIOTA HUMANA
10-12 de octubre de 2026 Santiago de Chile, Chile eventos@insp.clwww.insp.cl/seminario2026
XIX / XX CONGRESO NACIONAL DE BIOQUÍMICA - MEXICO 11–16 octubre 2026 Sociedad Mexicana de Bioquímica Cancún Center, Cancún, México https://smb.org.mx
30TH INTERNATIONAL CPOCT SYMPOSIUM 14–16 octubre 2026 Pittsburgh, Pennsylvania, USA ADLM. https://myadlm.org/meetings-and-events/international-cpoct-symposiumMyADLM
27th IFCC WorldLab 2026 25–29 octubre 2026 International Convention & Expo Centre, Nueva Delhi, India www.ifccnewdelhi2026.org
MICROBIOME > COLD SPRING HARBOR LABORATORY MEETING 27–31 de octubre 2026 –meetings@cshl.eduhttps://meetings.cshl.edu/meetings.aspx?meet=BIOME
JORNADA DE FARMACIA Y NUEVAS TECNOLOGÍAS
17-19 de noviembre de 2026 Bogotá, Colombia jornada@farmacia2026.comwww.farmacia2026.com/jornada
CONGRESO INTERNACIONAL DE NUEVAS TECNOLOGÍAS EN LA MEDICINA
20-23 de noviembre de 2026 Ciudad de Panamá, Panamá info@tecnologia2026.comwww.tecnologia2026.com
CONGRESO SAB 2026 25 al 27 de noviembre 2026 LIV Reunión Anual de la Sociedad Argentina de Biofísica https://biofisica.org.ar/congreso-2026/congreso-2026-informacion-general/
XXVII CONGRESO LATINOAMERICANO DE BIOQUIMICA CLINICA XIX Congreso Nacional de la Sociedad Boliviana de Bioquímica Clínica. 7 al 11
de octubre 2026, Santa Cruz, Bolivia.
www.colabiocli.com/congreso-colabiocli-2026
IFCC WORLDLAB 2026
25 al 29 de octubre 2026, New Delhi, India.
www.ifccnewdelhi2026.org/
18º CONGRESO DE LA FEDERACION ASIA-PACIFICO DE BIOQUIMICA CLINICA Y MEDICINA DE LABORATORIO
2027 Kuala Lumpur, Malasya.
https://apfcbcongress2027.org
CURSOS ABA AUTOGESTION: Para realizar en el momento que se desee, autoinscripcion y exámen final con certificado. Inscripción permanente del 16 de marzo al 30 de noviembre 2026
Del área de Hematología:
- Claves para la interpretación y validación del hemograma automatizado. Detección de interferencias.
- Frotis y Morfología Mieloide. Pistas para la identificación de procesos neoplásicos y reactivos.
- Rol de la morfología de las células hemáticas en el laboratorio de urgencias.
Del área de control de calidad interno:
- Estrategias de CCI orientado a Química Clínica
- Estrategias de CCI orientado a: Hematología, Hemostasia, Citometría de Flujo
- Estrategias de CCI orientado a Biología Molecular
- Estrategias de CCI orientado a: Endocrinología, Marcadores Tumorales
- Estrategias de CCI orientado al Laboratorio de Microbiología
- Estrategias de CCI orientado a: pruebas rápidas de laboratorio, POCT
- Estrategias de CCI orientado a inmunología
Otros:
- Normas ISO Utilidad y Aplicación para el Laboratorio Bioquímico
- Calidad en laboratorios de genética forense
- Examen de orina. Aspectos citológicos y microbiológicos
- Curso integral sobre líquidos de punción con tópicos de urgencia
https://aba-online.org.ar/cursos-autogestionados-2026